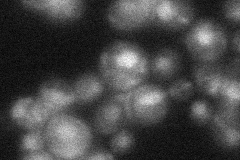
YGR278W
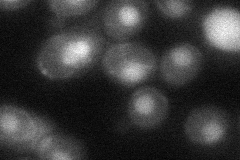
YGR278W
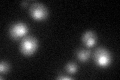
YGR278W
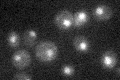
YGR278W

View description
Essential protein, component of a complex containing Cef1p, has similarity to S. pombe Cwf22p; putative spliceosomal component, based on computational analysis of large-scale protein-protein interaction data
Localization:
Intensity:
Fold change:
Significance:
-
C’ GFP library in SD

nucleus24.78 -
N' NOP1pr-GFP in SD

nucleus52.4291 -
N' TEF2pr-mCherry in SD

nucleus63.3651 -
N' NATIVEpr-GFP in SD
nucleus26.0239 -
N' TEF2pr-VC and Cyto-VN in SD
nucleus33.8308 -
C’ GFP library in SD+DTT
nucleus25.971.04No -
C’ GFP library in SD+H2O2

nucleus28.71.15No -
C’ GFP library in Starvation Media
nucleus21.770.87No -
C’ GFP library on the background of Pup2-DaMP

nucleus -
C’ GFP library on the background of CCT mutant

nucleus24.81511.00112No
